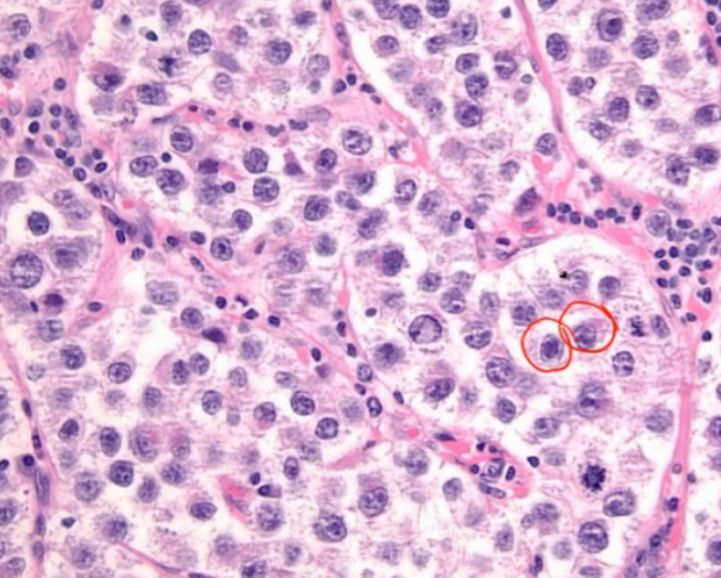
Flashcard 15 image

The histology image below has lymphocytes and plasma cells in the endometrium, which is indicative of _____

The image shows _____ bodies which are seen in Granulosa cell tumour.

_____ is a testicular germ cell tumor that forms a hemorrhagic mass with necrosis

The gross appearance of inflammatory breast cancer is often described as resembling an _____ (due to invasion of lymphatic spaces)

_____ is a malignant testicular tumor comprised of large cells with clear cytoplasm and central nuclei, sometimes described as a "fried egg" appearance
Powder burn spots over the peritoneum are seen in _____.

_____ emboli are characterized by squamous cells and keratin debris in the embolus
Small _____philic colloid amyloid bodies called corpora amylacea are frequently seen within a prostatic follicle.
_____ are the most common changes in pre-menopausal breast
The two most common subtypes of ovarian surface epithelial tumors are _____ and mucinous; both usually cystic
Diseases of Male Genital Tract
Flashcards
Testicular Tumors
Flashcards
Prostate Pathology
Flashcards
Diseases of Female Genital Tract
Flashcards
Cervical Pathology and Neoplasia
Flashcards
Endometrial Pathology
Flashcards
Ovarian Diseases and Tumors
Flashcards
Gestational Trophoblastic Disease
Flashcards
Placental Pathology
Flashcards
Sexually Transmitted Infections
Flashcards
Get full access to all flashcards, spaced repetition, and progress tracking.
Start For Free